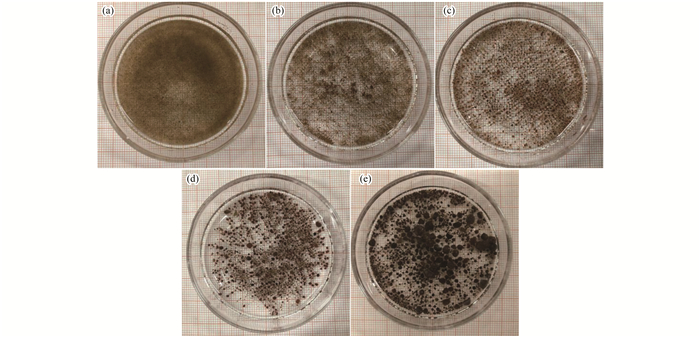

厭氧氨氧化(anaerobic ammonium oxidation, ANAMMOX)因為無需曝氣、節(jié)省碳源、產(chǎn)泥量少, 可節(jié)約能耗和降低運行成本, 成為目前污水處理脫氮工藝的研究熱點.但厭氧氨氧化菌的世代周期長達11 d, 且對環(huán)境因素變化敏感, 因此有效富集和截留厭氧氨氧化菌是保證工藝穩(wěn)定運行、提高脫氮效率的必要條件.顆粒污泥具有良好的沉降性能和抗沖擊能力, 可保持大量生物量, 形成厭氧氨氧化顆粒污泥是保障良好的脫氮性能的重要形式.
現(xiàn)階段學者們對厭氧氨氧化顆粒污泥的形成機制和快速啟動進行了大量研究, 然而厭氧氨氧化顆粒污泥是一個復雜的微生物共生系統(tǒng), 不同的培養(yǎng)條件如水流剪切力、基質(zhì)濃度、氮負荷導致顆粒污泥性質(zhì)具有差異性, 這些差異性還不明確.膨脹顆粒污泥床(expanded granular sludge bed, EGSB)反應器和上升式厭氧污泥床(up-flow anaerobic sludge bed, UASB)反應器在培養(yǎng)厭氧氨氧化顆粒污泥方面應用廣泛.然而兩種反應器在結構、性能和運行參數(shù)上都有所不同, 勢必導致培養(yǎng)的厭氧氨氧化顆粒污泥特性及微生物群落結構上有所差異, 進而影響其脫氮性能.
本文在不同的上升流速、水力停留時間、基質(zhì)濃度以及氮負荷的培養(yǎng)條件下, 研究了EGSB和UASB反應器中厭氧氨氧化顆粒污泥特性的差異性, 并采用高通量測序法分析了不同運行條件下厭氧氨氧化顆粒污泥顆粒的微生物種群特征, 以期為厭氧氨氧化顆粒污泥的工程化應用提供參考.
1 材料與方法
1.1 反應器與實驗用水
EGSB反應器反應區(qū)高度為60 cm, 內(nèi)徑為6 cm, 外徑12 cm, 有效容積約為1.7 L, 高徑比約為10:1, 通過內(nèi)循環(huán)系統(tǒng)控制水流上升速度, 反應器頂部三相分離區(qū)澄清液直接經(jīng)循環(huán)泵從底部回流, 不接觸空氣.UASB反應器反應區(qū)的內(nèi)徑8 cm, 沉淀區(qū)內(nèi)徑10 cm, 高127 cm, 持水高度120 cm, 有效容積為19.7 L.兩個反應器均由有機玻璃制成, 密封保障厭氧環(huán)境, 依靠外層的水浴夾套保持溫度在(32±1)℃, 整體用遮陽塑料膜蓋住避光, 并通過蠕動泵控制進水流量.
實驗用水采用人工模擬廢水, 其中的氨氮和亞硝酸鹽通過添加NH4Cl和NaNO2獲得, 濃度按需配比.CaC12 0.18 g·L-1, KH2PO4 0.03 g·L-1, MgSO4 0.30 g·L-1, KHCO3 0.50 g·L-1, 1 L配水添加1 mL微量元素Ⅰ和Ⅱ.微量元素Ⅰ組分(g·L-1):EDTA 5, FeSO4 5;微量元素Ⅱ組分(g·L-1):EDTA 15, ZnSO4·7H2O 0.43, CoCl2·6H2O 0.24, MnCl2·4H2O 0.99, CuSO4·5H2O 0.25, NaMoO4·2H2O 0.22, NiCl2·6H2O 0.19, NaSeO4·10H2O 0.21, H3BO4 0.014.進水pH控制在7.5±0.5.
1.2 污泥來源
接種污泥取自實驗室培養(yǎng)的成熟的厭氧氨氧化絮狀污泥, SS=5.2 g·L-1, VSS=2.4 g·L-1, VSS/SS=46.20%, 總氮容積去除負荷為0.7 kg·(m3·d)-1.EGSB和UASB反應器種泥接種體積比分別為60%和50%.采用EGSB和UASB反應器連續(xù)培養(yǎng)厭氧氨氧化顆粒污泥, 經(jīng)過384 d的培養(yǎng), 兩者均獲得了較好的脫氮效果, 且均形成顆粒污泥.培養(yǎng)過程中, 取反應器啟動時的種泥, EGSB反應器運行第53、177和384 d以及UASB反應器運行第384 d時反應器內(nèi)混合均勻的污泥樣品. 5個污泥樣品名稱分別標記為種泥、E.53 d、E.177 d、E.384 d和U.384 d.取樣期間反應器的運行工況和水質(zhì)處理效果如表 1所示.

表 1 取樣期間反應器的運行工況及處理效能
1.3 指標測定
污泥宏觀形態(tài)特征采用iPhone8后置攝像頭拍攝記錄, 微觀形態(tài)與結構特征采用微生物光學顯微鏡(OLYMPUS CX41, 日本)和掃描電子顯微鏡(SEM, HITACHI S-4300, 日本)進行.掃描電鏡樣品制備參照Wu等[11]的方法進行, 具體如下:首先, 挑選部分顆粒污泥用磷酸緩沖液(pH=6.8)沖洗3~5次, 去除顆粒表面雜質(zhì);加入戊二醛(質(zhì)量濃度=2.5%、pH=6.8)完全淹沒泥樣, 4℃冰箱固定12 h;分別使用不同濃度乙醇(50%、70%、80%和90%)依次脫水10~15 min, 再用100%無水乙醇脫水3次, 每次10~15 min;用乙醇:乙酸異戊酯(1:1)混合溶液、純乙酸異戊酯各置換1次、每次15 min, 干燥8 h;采用離子濺射鍍膜儀(IB-5Giko)在樣品表面鍍金屬膜(厚度為1.5 mm);置于掃描電鏡下觀察待檢樣的微觀性狀及結構特征.顆粒污泥粒徑采用激光粒度儀(MASTERSIZER 3000, Malvern, UK)進行測定.
1.4 微生物分析
采用Illumina MiSeq測序平臺對5個樣品微生物進行測序, 實驗流程包括微生物組總DNA提取、目標片段PCR擴增、擴增產(chǎn)物回收純化、擴增產(chǎn)物熒光定量、MiSeq文庫構建和MiSeq測序.
2 結果與討論
2.1 不同培養(yǎng)條件厭氧氨氧化顆粒污泥理化性質(zhì)
2.1.1 表觀形態(tài)
不同培養(yǎng)條件下污泥表觀顏色與形態(tài)如圖 1所示.接種污泥顏色為棕色, 呈絮狀, 結構較為松散.EGSB反應器運行53 d出現(xiàn)小顆粒, 顏色由接種時的棕色進一步加深, 177 d后顆粒污泥粒徑增長, 顏色磚紅色, 第384 d污泥顆粒顏色加深, 顆粒化過程中污泥由棕色向棕紅、紅褐色轉(zhuǎn)變.UASB反應器中培養(yǎng)384 d的顆粒污泥顏色暗紅, 與EGSB反應器中第384 d的污泥相比顏色更暗.厭氧氨氧化菌因含有一系列血紅素c蛋白(細胞色素c)而顯示獨特的紅色.紅色可以用作粗略評估比活度和反應器容量的指標.在不同的氮加載速率下, 厭氧氨氧化顆粒污泥的顏色可能會從胭脂紅變?yōu)樽厣妥優(yōu)楹谏?
(a)種泥; (b)E.53 d; (c)E.177 d; (d)E. 384 d; (e)U. 384 d
圖 1 不同培養(yǎng)條件下ANAMMOX污泥宏觀形態(tài)
在顯微鏡下可以觀察到厭氧氨氧化污泥顆粒化的過程中的外觀變化, 起初厭氧氨氧化污泥呈不規(guī)則幾何形, 微生物或分散或團簇在一起, 邊緣呈現(xiàn)毛刺狀(圖 2).經(jīng)過一段時間的培養(yǎng), 絮體吸附在一起, 微生物在胞外聚合物(extracellular polymeric substances, EPS)的作用下相互吸附黏合形成緊實的顆粒狀污泥.EPS是厭氧氨氧化顆粒污泥的重要組成部分, 它使細胞彼此粘附并促進微生物聚集, 有助于形成厭氧氨氧化顆粒污泥的水通道或氣體隧道(0.4~18.9 μm), 影響著厭氧氨氧化顆粒污泥的質(zhì)量傳遞和密度.EGSB反應器第384 d的顆粒污泥可以看出顆粒污泥形態(tài)圓滑飽滿, 內(nèi)部密實, 外層包裹著一層瓊脂狀的胞外聚合物, 與UASB反應器第384 d的顆粒污泥相比, 輪廓更為光滑, 主要原因是在EGSB反應器中有更高的上升流速, 較強水力沖刷使得顆粒污泥表面更光滑.
(a)種泥; (b)E. 53d;(e)E.177d;(d)E. 384d;(e)U. 384d
圖 2 不同培養(yǎng)條件下ANAMMOX污泥顯微鏡形態(tài)
2.1.2 顆粒污泥粒徑分布
粒徑分布是厭氧氨氧污泥顆粒化進程的一個重要表征參數(shù).厭氧氨氧化污泥的粒徑隨著反應器運行而變化.起初接種污泥粒徑 < 0.2 mm占67.10%(圖 3), 平均粒徑為0.15 mm.EGSB反應器運行至53 d, 粒徑 < 0.2 mm的顆粒減少, >0.2 mm的顆粒增多, 出現(xiàn)了>1.5 mm粒徑的顆粒, < 0.2、0.2~1.5和>1.5 mm的粒徑數(shù)量占比分別為15.23%、83.77%和1.00%, 平均粒徑增長到0.47 mm.EGSB反應器運行至177 d, 小粒徑進一步向大粒徑轉(zhuǎn)變, 各粒徑占比為6.05%、72.11%和21.84%, 運行至384 d時, 出現(xiàn)>3 mm粒徑的顆粒污泥, 粒徑占比由小到大分別為7.40%、58.90%、32.04%和1.66%, 平均粒徑達到1.17 mm, 相比接種時增長了7.8倍.培養(yǎng)過程中, 粒徑 < 0.2 mm的污泥呈現(xiàn)先減少后略微增加至穩(wěn)定的趨勢, 原因一方面是小顆粒污泥不斷增長成大顆粒污泥, 在啟動初期粒徑變化最為明顯;另一方面是有微生物不斷繁殖增長, 聚集黏合成細小顆粒, 生成小顆粒的速度與顆粒增長的速度達到平衡.從顆粒污泥的粒徑分布變化可以看出, 反應器中的顆粒粒徑在0.2~1.5 mm的占比最大.UASB反應器運行至384 d時, 各范圍的粒徑占比為6.06%、60.05%、25.25%和8.64%, 平均粒徑達到1.21 mm.對比EGSB反應器中的顆粒, UASB反應器中粒徑>3 mm的顆粒占比更大, 且最大粒徑為3.8 mm, 而EGSB反應器中最大粒徑為3.1 mm, 主要的影響因素是水力條件.本實驗中粒徑在0.2~1.5 mm之間的占比最大, 有研究表明當顆粒直徑為0.5~0.9 mm時, 厭氧氨氧化菌的豐度、活性和反應速率均得到提高, 1.0~1.5 mm粒徑的厭氧氨氧化顆粒污泥具有最高活性.具體聯(lián)系污水寶或參見http://www.bnynw.com更多相關技術文檔。

圖 3 不同培養(yǎng)條件下ANAMMOX污泥粒徑分布
2.1.3 顆粒污泥掃描電鏡分析
圖 4為不同時期的厭氧氨氧化污泥的掃描電鏡圖.起初接種污泥可以看到少量的桿菌和黏性物質(zhì), 由絲狀纖維物質(zhì)相互連接.隨著顆粒的增大, 細菌微生物密集的聚集起來, 在EGSB反應器第177 d和UASB反應器第384 d, 顆粒污泥表面有大量球型細菌, EGSB反應器運行384 d, 顆粒污泥中大量球型菌、短桿菌、絲狀菌大量共存.研究報道厭氧氨氧化顆粒污泥主要以球形或卵型的球菌聚集體為主, 粒徑在0.8~1 μm之間.目前普遍認為, 厭氧氨氧化顆粒污泥包括4層結構(顆粒, 亞基, 微生物細胞簇和單細胞).Kang等的研究發(fā)現(xiàn), 紅色厭氧氨氧化顆粒污泥的表面具有類似于火山口的結構, 覆蓋大量類似厭氧氨氧化細菌的球菌;棕色厭氧氨氧化顆粒污泥表面疏松, 幾乎沒有球菌存在, 大量絲狀細菌和EPS相互纏結;而黑色厭氧氨氧化顆粒污泥的表面致密而光滑, 被大量的無機物覆蓋, 看不到細菌.

(a)種泥; (b)E.53d;(c)E. 177d;(d)E. 384d;(e)U. 384d
圖 4 不同培養(yǎng)條件下ANAMMOX污泥SEM圖像
2.2 不同培養(yǎng)條件厭氧氨氧化顆粒污泥微生物群落結構分析
2.2.1 微生物多樣性及豐度分析
5個污泥樣品的測序量和OTU數(shù)較為接近, 分別在35 122~38 257和4 805~5 715之間.對于微生物群落而言, 有多種指數(shù)來反映其α多樣性.不同的指數(shù)對于衡量群落多樣性的側(cè)重點各不相同, Chao1或ACE指數(shù)側(cè)重于體現(xiàn)群落的豐富度(即群落中微生物成員如OTU的數(shù)量), 一般而言, Chao1或ACE指數(shù)越大, 表明群落的豐富度越高.由表 2可以看出接種污泥的Chao1和ACE指數(shù)均為1 398, 經(jīng)EGSB反應器運行53~177 d, Chao1和ACE指數(shù)呈現(xiàn)下降趨勢, 分別下降到1 219.83和1 376.72, 而培養(yǎng)至384 d時, Chao1和ACE指數(shù)上升到1 344.54和1 376.72, 和接種時的指數(shù)相差不大.說明反應器啟動初期, 由于生存環(huán)境發(fā)生改變, 厭氧氨氧化顆粒污泥的種群多樣性先下降, 在微生物適應了新的生長環(huán)境, 種群多樣性又進一步豐富起來.而在UASB反應器運行384 d之后, 發(fā)現(xiàn)Chao1和ACE指數(shù)比接種污泥有所降低, 分別為1 111.07和1 114.34, 同時也低于EGSB反應器的384 d污泥樣品, 這說明UASB反應系統(tǒng)中微生物種群較EGSB反應系統(tǒng)更為單一.與Chao1和ACE指數(shù)不同, Simpson指數(shù)更傾向于反映群落的均勻度(即各成員間的豐度差異大小), Simpson指數(shù)值越高, 表明優(yōu)勢菌群占總體生物菌群比例越大.而Shannon指數(shù)綜合考慮了群落的豐富度和均勻度, 指示了生物群落組成復雜程度, 其值越大, 表明群落復雜程度越大. 5個樣品中Simpson指數(shù)均在0.97以上, 差別不大, 說明本研究條件下不論在UASB反應器中還是EGSB反應器中, 成熟的厭氧氨氧化污泥顆粒化過程的優(yōu)勢種群占總體生物種群比例穩(wěn)定.Shannon指數(shù)在EGSB反應器運行第53 d由接種時的7.62降低到7.09, 隨后隨著培養(yǎng)時間的增長而增加, 到384 d時增長到7.52, 說明群落的復雜程度與種群多樣性呈一樣的變化趨勢.而UASB反應器中384 d的Shannon指數(shù)為7.18, 均低于接種污泥和EGSB反應器第384 d的污泥, 表明UASB反應系統(tǒng)中的微生物的多樣性略低.

表 2 菌群微生物多樣性指數(shù)
2.2.2 各階段微生物在門分類層面上的比對
從門分類層面上的比對各階段的微生物種群, 結果如圖 5所示, 5個樣品中豐富度占比較大的有變形菌門(Proteobacteria)、浮霉菌門(Planctomycetes)、擬桿菌門(Bacteroidetes)、綠彎菌門(Chloroflexi)、Patescibacteria門、放線菌門(Actinobacteria)、厚壁菌門(Firmicutes).其中變形菌門(Proteobacteria)在5個樣品中的占最大比例, 在35.61%~50.84%之間, 是各個樣品的優(yōu)勢種群.厭氧氨氧化菌屬于浮霉菌門, 接種污泥中浮霉菌門只有3.31%, 而在EGSB反應器運行53 d達到13.95%, 在177 d氮負荷為2.8kg·(m3·d)-1時浮霉菌門達到最大富集為23.45%, 但當容積氮負荷進一步升高至5.83kg·(m3·d)-1時, 浮霉菌門的比例下降至13.30%.而UASB反應器運行384 d后浮霉菌門達到12.27%, 略低于EGSB的第384 d, 該運行工況的氮負荷只有1.8kg·(m3·d)-1.氮去除負荷的波動直接影響著反應器優(yōu)勢微生物群落結構的演變.在運行384 d后, 兩個反應器中的微生物群落結構比較類似, 其中變形菌門(Proteobacteria)和浮霉菌門(Planctomycetes)是最主要的兩大門類, 同時也存在著一定比例的厭氧異養(yǎng)菌如擬桿菌門和厚壁菌門.由于涉及到脫氮功能微生物主要來自變形菌門, 浮霉菌門和硝化螺旋菌門3種, 而運行后各階段這3種菌門占總細菌的54.72%~63.14%, 因此脫氮效果較好, 達到84%~90%.

圖 5 各樣品細菌分類(門)的群落組成相對百分比
2.2.3 各階段微生物在屬分類層面上的比對
對具有脫氮性能的變形菌門和浮霉菌門進行屬水平分析.Denitratisoma和Limnobacter是變形菌門的主要菌種, 在接種污泥中分別占1.80%和8.60%(圖 6), 其中Denitratisoma在兩個反應器運行期間都有所增長, 在EGSB反應器第53、177和384 d分別占比19.47%、12.17%和14.98%, 在UASB反應器第384 d占15.66%, 增長達到5倍以上.而Limnobacter在EGSB反應器中的比例先下降后升高, 在EGSB運行至177 d達到最低, 只占0.95%, 而到384 d時增長到9.01%與接種污泥中所占比例相當.而在UASB反應器中增長到15.50%, 是EGSB反應器中的1.7倍, 有所差異.Denitratisoma是反硝化菌, 在缺氧狀態(tài)下完成反硝化作用, 需要消耗有機碳源, 由于厭氧氨氧化反應是產(chǎn)生硝態(tài)氮的過程, 反應器中也存在細胞代謝或微生物死亡后的有機物, 可被反硝化菌利用將硝態(tài)氮轉(zhuǎn)化為亞硝進而轉(zhuǎn)化為氮氣進一步提高氮的去除率.Limnobacter屬經(jīng)常在各種環(huán)境, 如表面海水, 大洋深處, 人體腸道, 和火山沉積物中被發(fā)現(xiàn).該屬目前只有L. thiooxidans和L. litoralis兩個種被分離和鑒定, 這兩個物種都是異養(yǎng)的, 在有機底物(如琥珀酸鹽)存在下, 耗氧并將硫代硫酸鹽氧化成硫酸鹽獲得額外能源.Chen等的研究發(fā)現(xiàn)在厭氧甲烷氧化(anaerobic methane oxidizing, AOM)環(huán)境中, Limnobacter菌株可能以通過AOM活性產(chǎn)生的有機物質(zhì)為生, 隨后可能通過提供硫氧化產(chǎn)生的硫酸鹽而對AOM群落做出貢獻.

圖 6 各樣品細菌分類(屬)的群落組成相對百分比
在浮霉菌門中共檢測出3種主要屬, 其中Candidatus Brocadia和Candidatus Kuenenia屬是厭氧氨氧化菌, 接種污泥中Candidatus Brocadia和Candidatus Kuenenia屬所占比例為1.95%和0.32%.在EGSB反應器運行第53、177和384 d時Candidatus Brocadia占比分別為11.25%、10.63%和7.53%(表 3), 說明在運行初期Candidatus Brocadia屬能夠快速富集, 而隨著氮負荷的升高, 所占比例有所降低;而Candidatus Kuenenia屬在占比也有所增長分別為1.21%、0.89%和1.61%, 在EGSB反應器中Candidatus Brocadia屬比例始終高于Candidatus Kuenenia屬.UASB反應器中不同, 384 d時, Candidatus Brocadia屬占比為3.69%, 而Candidatus Kuenenia屬為7.54%, 說明在UASB反應器中厭氧氨氧化的優(yōu)勢屬種為Candidatus Kuenenia屬.

表 3 不同研究中EGSB和UASB反應器厭氧氨氧化優(yōu)勢菌屬
對于反應系統(tǒng)中ANAMMOX的優(yōu)勢菌種, 有研究發(fā)現(xiàn)Candidatus Brocadia在NO2--N濃度高于17~30μmol·L-1時Candidatus Brocadia較Candidatus Kuenenia具有更高增殖速率, 屬于生長率高但基質(zhì)親和力差的r-對策;而Candidatus Kuenenia較Candidatus Brocadia對NO2--N的親和力更強, 可以利用較低濃度的亞硝態(tài)氮, 而且具有更高的耐受NO2--N抑制能力, 屬于生長率低但基質(zhì)親和力好的k-對策.不同屬厭氧氨氧化菌適宜生存環(huán)境不同, 在不同的上升流速下, 反應器內(nèi)污泥濃度以及廢水中營養(yǎng)成分、微量元素等的分布均不相同, 也會造成厭氧氨氧化菌優(yōu)勢菌種存在差異或優(yōu)勢菌屬的遷移.例如譚錫誠等的研究中發(fā)現(xiàn)隨著進水氨氮濃度的提高, 反應系統(tǒng)中ANAMMOX的優(yōu)勢菌種由Candidatus Brocadia(100%)轉(zhuǎn)變?yōu)镃andidatus Jettenia(50%)和Candidatus Kuenenia(30%)的混合菌種.佟智達的研究發(fā)現(xiàn)在0.5、2、5、8 m·h-1的不同上升流速下, 富集得到的厭氧氨氧化菌中優(yōu)勢菌種不同, 分別為Candidatus Kuenenia、Asahi BRW2、Candidatus Brocadia和Candidatus Anammoxoglobus屬.目前, 在厭氧氨氧化富集過程中菌種改變的原因還未有定論, 還需要做進一步分析.
2.2.4 環(huán)境條件與微生物群落之間的相關性
典范對應分析(CCA)用于評估環(huán)境條件對各種系統(tǒng)中微生物群落動態(tài)的影響.CCA的結果揭示了環(huán)境參數(shù)與5個樣本之間的相關性, 如圖 7所示.厭氧氨氧化顆粒污泥培養(yǎng)過程中的細菌群落結構發(fā)生改變, 其中EGSB第177 d的菌落結構差異性最大, 隨著培養(yǎng)時間增長, 微生物適應性增強, 群落結構差異減小.分析表明優(yōu)勢菌屬Candidatus Brocadia與v、NRR存在較強正相關而與HRT呈較強負相關, Candidatus Kuenenia與NRE、NRR、HRT成正相關, 而與v呈負相關.

圖 7 水質(zhì)參數(shù)與菌群結果的典范對應分析
3 結論
(1) EGSB和UASB反應器運行至384 d, 厭氧氨氧化顆粒污泥平均粒徑分別為1.17 mm和1.21 mm, 其中0.2~1.5 mm粒徑范圍的顆粒占比最大, 分別為58.90%和60.05%.UASB反應器中>3 mm的粒徑占比多于EGSB反應器, 分別為8.64%和1.66%, 表明UASB反應器低速的水力條件更容易培養(yǎng)出粒徑大的顆粒污泥.
(2) 在厭氧氨氧化顆粒污泥培養(yǎng)期間, 污泥顏色由棕色變?yōu)樯罴t褐色, 掃描電鏡結果表明不同運行條件下的污泥菌群以短桿菌、球型菌為主.變形菌門是主要優(yōu)勢菌群, 同時浮霉菌門含量大幅提高.Candidatus Brocadia和Candidatus Kuenenia屬是厭氧氨氧化顆粒污泥主要菌屬, 在EGSB反應器中Candidatus Brocadia屬是優(yōu)勢菌屬占7.53%, 而UASB反應器中Candidatus Kuenenia屬是優(yōu)勢種群, 占7.54%.
(3) 優(yōu)勢菌屬Candidatus Brocadia豐度與v、NRR存在較強正相關而與HRT呈較強負相關, Candidatus Kuenenia豐度與NRE、NRR、HRT成正相關, 而與v呈負相關.(來源:蘇州科技大學環(huán)境科學與工程學院 作者: 姜瀅)


